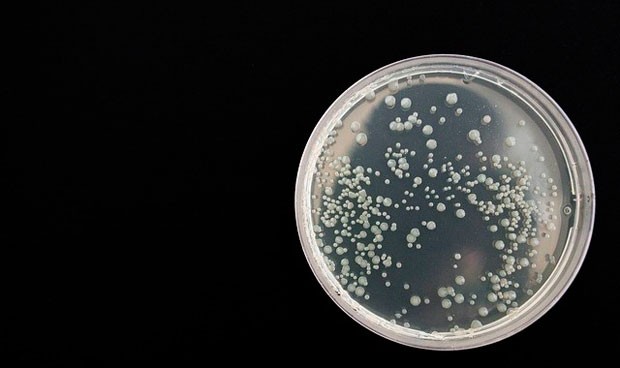
Descubren un nuevo hongo resistente a fármacos que emerge a nivel mundial

El estudio se ha publicado en la revista Annals of Internal Medicina.
La revista Annals of Internal Medicina ha publicado un estudio en el que expertos alertan de la aparición de un nuevo hongo resistente a los medicamentos que está emergiendo a nivel mundial. Su nombre es 'Candida auris' y los investigadores inciden en la detección temprana como clave para evitar la propagación de este hongo.
Por ello, los médicos deben conocer los factores de riesgo y evaluar a los pacientes sospechosos de infección o colonización. 'Candida auris' es un hongo potencialmente mortal que causa infecciones en el torrente sanguíneo e intraabdominal. Su aparición ha puesto de relieve las brechas en la capacidad de identificación de hongos en todo el mundo.
"Su resistencia a los medicamentos no tiene precedentes entre las levaduras patógenas para humanos conocidas. La mayoría de las especies de Candida no se cree que se transmitan en entornos de atención médica y no requieren medidas de control de infecciones cuando un paciente desarrolla una infección", explican los expertos.
Sin embargo, a diferencia de otras especies de Candida, 'C. auris' "se transmite comúnmente entre pacientes en entornos de atención médica, lo que provoca brotes que no solo afectan a una sola instalación, sino que también se propagan a través de redes de instalaciones", continúan.
La capacidad de 'C. auris' para persistir y contaminar el entorno de atención médica y los dispositivos médicos "probablemente contribuye a estos brotes".
Factores de riesgo
Según los expertos de los Centros para el Control y la Prevención de Enfermedades (CDC), la hospitalización previa en un país con transmisión de 'C. auris' "es un factor de riesgo conocido de infección o colonización, al igual que recibir atención médica en hospitales de cuidados agudos a largo plazo y hogares de ancianos que atienden a pacientes muy enfermos que necesitan ventiladores a largo plazo".
Las hospitalizaciones frecuentes y la recepción de múltiples ciclos de antibióticos de muy amplio espectro también son factores de riesgo importantes. Por ello, los autores insisten en que estar en alerta máxima por estos factores de riesgo y evaluar a los pacientes apropiados es la clave para controlar la propagación de 'C. auris'.
 REGÍSTRATE GRATIS
REGÍSTRATE GRATIS
PARA SEGUIR LEYENDO
 ¿Ya eres premium? Inicia sesión
¿Ya eres premium? Inicia sesión

Aviso importante
El usuario desde el que está intentando acceder a este contenido no está registrado como profesional autorizado para acceder a esta información. Esta noticia informa sobre novedades farmacológicas y, por ley, está reservada a profesionales de la salud habilitados para la prescripción o dispensación de medicamentos.
Volver a la portada de Redacción Médica
Las informaciones publicadas en Redacción Médica contienen afirmaciones, datos y declaraciones procedentes de instituciones oficiales y profesionales sanitarios. No obstante, ante cualquier duda relacionada con su salud, consulte con su especialista sanitario correspondiente.